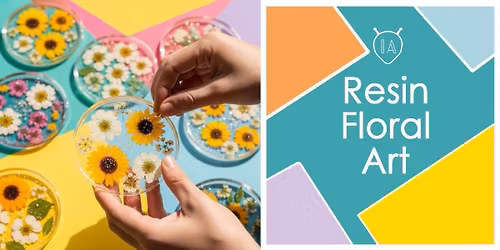
Resin FLORAL Art

Advertisement
Nashik News: Sayaji Shinde Leads Massive Protest Against Felling of 1,700+ Trees for Kumbh Mela 2026–28 | “Trees Are Our Parents”A major environmental storm is brewing in Nashik, with actor Sayaji Shinde, activists, and thousands of citizens rising against the proposed felling of 1,700–1,825 trees in the Tapovan–Sadhugram area for preparations ahead of the Simhastha Kumbh Mela 2026–28 / 2027. What began as a small, local objection has now turned into one of the largest green movements the city has seen in recent years.
Why Are Trees Being Cut in Nashik?
Sayaji Shinde Leads Massive Protest Bold 3X Green Win
The Nashik Municipal Corporation (NMC) has proposed clearing parts of Tapovan-Sadhugram to expand the settlement area for sadhus and mahants.
2015 Sadhugram size: ~350 acres
Proposed 2027 Sadhugram: 1,152 acres
Expected visitors: 10 lakh sadhus and mahants
Trees slated for felling: 1,700–1,825, many of them native, old, and sturdy
Citizens and environmentalists argue that clearing this many trees—especially in a no-development zone—goes against Nashik’s “Green Kumbh” vision.
Actor Sayaji Shinde Joins the Movement
Popular Marathi and Indian cinema actor Sayaji Shinde, known for planting over 7 lakh native trees across the Sahyadris, has publicly opposed the mass felling.
Shinde strongly stated:
“Trees are our parents. If one tree is cut, a hundred people are ready to die—cut down the trees.”
He visited Tapovan, met protesting citizens, and expressed full support for the agitation. His entry has given the movement a powerful boost at both local and statewide levels.
Growing Protest: 3,000+ Signatures, Chipko-Style Movement, PIL in High Court
Sayaji Shinde Leads Massive Protest Bold 3X Green Win
The movement has rapidly escalated into a citywide environmental campaign:
600+ objections filed in the first public hearing
Citizens conducted a Chipko-style tree-hugging protest on November 20
3,000 signatures collected within hours
A Public Interest Litigation (PIL) is being prepared for the High Court
Activists and organisations from Mumbai have joined hands
A large-scale social media awareness drive is launching soon
Environmentalists insist old, naturally grown trees cannot be replaced by saplings
Raju Desale and other activists confirm that the next two days will involve a joint physical inspection of the Tapovan area by experts, celebrities, and organisations to decide the agitation’s direction.
Why Tapovan Is So Significant
Tapovan literally translates to “sacred grove,” and historically, the region has been treated as a devrai—a natural forest protected from human interference.
Shinde himself calls the lands he reforests “devrai,” meaning they must never be cut once grown.
Cutting trees in a region with such cultural, spiritual, and ecological significance has intensified the public’s anger.
NMC and Government Stand
Sayaji Shinde Leads Massive Protest Bold 3X Green Win
Water Conservation Minister Girish Mahajan has stated:
Trees will not be forcibly cut
For every tree cut, 10 new trees will be planted
However, activists dispute this claim, arguing that saplings do not compensate for the loss of decades-old native species, especially without long-term maintenance.
The government is preparing to spend Rs 3,700 crore on city development, airport expansion, and Kumbh infrastructure—yet much of the plan has drawn criticism due to:
Lack of transparency
Proposal violating the “no-development zone” designation
Cutting even trees previously planted by NMC itself
Plans to lease parts of the area for MICE (Meetings, Incentives, Conferences & Exhibitions) for 33 years
Why Citizens Are Angry: The Core Arguments
Environmentalists and common citizens argue that:
Nashik’s future cannot be compromised for temporary arrangements
Old native trees ensure natural balance, shade, clean air, and ecological stability
People have a right to protect public natural assets
The “Green Kumbh” slogan becomes meaningless if 1,800+ trees are destroyed
Residents are demanding an alternative location for Sadhugram that does not involve ecological damage.
Sayaji Shinde Leads Massive Protest: What Happens Next?
With growing celebrity participation, massive citizen support, and national attention, Nashik is witnessing a historic environmental movement.
The next two days will decide the final blueprint of protests, tree-protection initiatives, and legal actions.
One thing is clear:
Nashik is united to save Tapovan.
Note: All information and images used in this content are sourced from Google. They are used here for informational and illustrative purposes only.
FAQ: Sayaji Shinde Leads Massive Protest to Save Tapovan Trees
Sayaji Shinde Leads Massive Protest Bold 3X Green Win
1. Why is the headline “Sayaji Shinde Leads Massive Protest” gaining so much attention in Nashik?
The headline “Sayaji Shinde Leads Massive Protest” is making waves because the popular actor has stepped in to support citizens opposing the felling of 1,700–1,825 native trees in Tapovan–Sadhugram for the upcoming Simhastha Kumbh Mela preparations. His involvement has brought credibility, visibility and momentum to the movement, turning a local agitation into a major environmental campaign.
2. What environmental issues are highlighted as “Sayaji Shinde Leads Massive Protest” in Tapovan?
The movement focuses on preventing the destruction of old, native, and ecologically vital trees in a zone historically known as a “sacred grove.” The protest exposes concerns about losing biodiversity, disturbing natural balance, and turning a no-development zone into a massive construction site for temporary Kumbh arrangements.
3. How does the phrase “Sayaji Shinde Leads Massive Protest” reflect citizen participation?
“Sayaji Shinde Leads Massive Protest” reflects the unity of thousands of Nashik citizens, who have filed hundreds of objections, collected 3,000 signatures, and participated in Chipko-style tree-hugging demonstrations. The actor’s leadership has encouraged more residents to actively protect Tapovan’s green heritage.
4. What role does spiritual significance play when “Sayaji Shinde Leads Massive Protest”?
When “Sayaji Shinde Leads Massive Protest,” it highlights Tapovan’s identity as a sacred grove or “devrai,” traditionally protected from harm. This spiritual value adds depth to the movement, as people believe it is wrong to destroy a natural space connected with ancient traditions, meditation, and environmental respect.
5. How does the government respond as “Sayaji Shinde Leads Massive Protest” intensifies?
As “Sayaji Shinde Leads Massive Protest” gains strength, government authorities claim that trees will not be cut forcefully and promise ten new saplings for every tree felled. However, activists argue saplings cannot replace decades-old native trees and demand alternative solutions that do not sacrifice the environment.
6. How is “Sayaji Shinde Leads Massive Protest” influencing plans for Kumbh 2026–28?
“Sayaji Shinde Leads Massive Protest” is pushing officials to reconsider development plans for Sadhugram, question the chopping of trees in a no-development zone, and explore eco-friendly alternatives that balance religious arrangements with environmental preservation.
7. Why are environmentalists encouraged as “Sayaji Shinde Leads Massive Protest”?
Environmentalists feel empowered because “Sayaji Shinde Leads Massive Protest” brings public attention to long-standing issues, including lack of transparency in civic planning, misuse of public land, and inadequate maintenance of earlier plantation drives. His presence motivates volunteers and boosts public confidence.
8. What legal steps are emerging while “Sayaji Shinde Leads Massive Protest” continues?
As “Sayaji Shinde Leads Massive Protest” grows, activists are preparing a Public Interest Litigation (PIL) to be filed in the High Court. The legal action aims to challenge the proposed felling of trees, question the use of no-development zones, and ensure environmental laws are not violated.
9. How does Nashik benefit when “Sayaji Shinde Leads Massive Protest” raises awareness?
Nashik benefits because “Sayaji Shinde Leads Massive Protest” educates citizens about the importance of native trees, urban green cover, and ecological balance. The movement is creating long-term awareness about protecting common lands, demanding accountability, and securing a healthier future for the city.
10. What future actions are expected as “Sayaji Shinde Leads Massive Protest” gains momentum?
As “Sayaji Shinde Leads Massive Protest” advances, more inspections, social media campaigns, expert involvement, and on-ground initiatives are expected. The coming days will define the protest strategy, strengthen public unity, and possibly reshape the city’s environmental policies.
Advertisement
Event Venue & Nearby Stays
Kolkata,West Bangla,India
Tickets
Concerts, fests, parties, meetups - all the happenings, one place.